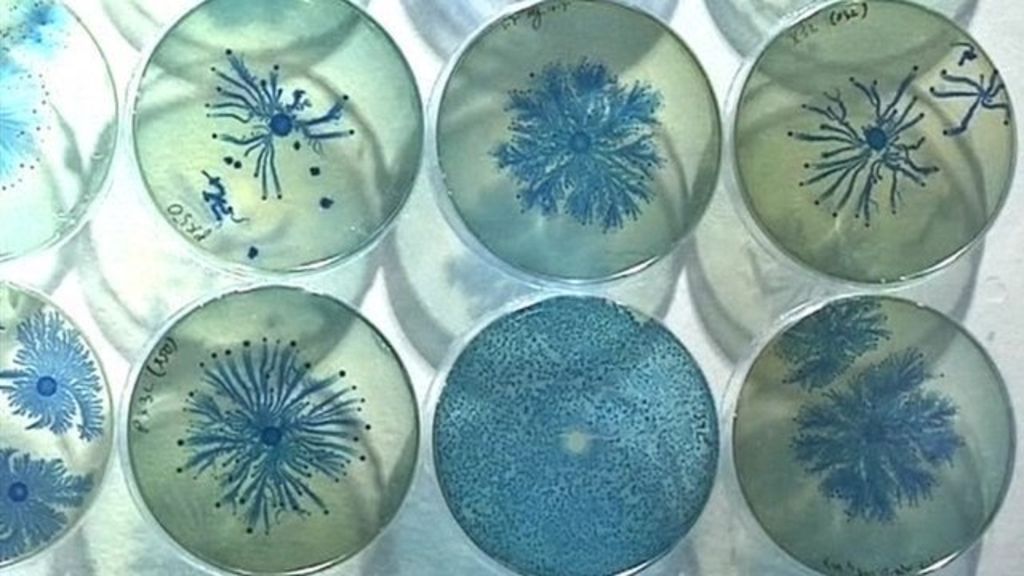

More resources
- View All
- Blogs
- Journal
- News
All Articles
Secondhand Market Outlook 2026: What Suppliers Should Expect When Selling to LATAM

The Global State of Second-Hand Clothing & Goods Part 2 (Trends, Policies and Innovations Driving the Future of Circular Fashion)

Store Return Pallets for Sale Your Guide to Sell Wholesale (2025 Edition)

Closing 2025 — Market Trends Shaping the Global Secondhand Wholesale Industry

Climate-Resilient Textiles- The Role of Secondhand Clothing in Disaster Relief and Humanitarian Aid

Maximizing Container Loads: Best Practices to Cut Shipping Costs

What Brands Get Wrong About Circular Design: Insights from the Reuse and Recycling Industry

From Donation to Destination: How Transparency Builds Trust in the Secondhand Supply Chain

Sustainable Promotions in Secondhand Wholesale: Gender Dynamics and Responsible Marketing

Beyond the Landfill Myth: Mapping the True Journey of Secondhand Clothing

What Does Working With Bank & Vogue Look Like As a Charity or Private Collector

Secondhand in the Age of Fast Retail- Competing with Ultra-Fast Fashion

The Rise of Brand Partnerships in Secondhand

Chile’s New Textile Import Rules: Opportunities for Conscious Trade

7 Impactful Second-Hand Wholesale Statistics For 2025

Border Enforcement Disruptions and Their Impact on the Secondhand Textile Trade in the U.S.

Why Transparency and Traceability Matter in the Secondhand Supply Chain

The State of Credential Clothing in Latin America In 2025

Evolving Pricing Models in the Secondhand Wholesale Industry: Auctions vs. Direct Sourcing

The Global State of Second-Hand Clothing & Goods Part 1 (Trends, Stats & Sustainability)

Rag News: The Future of Used Clothing: Insights, Metrics & Market Moves

Measuring & Reporting Circularity: A Guide for Secondhand Clothing Wholesalers

Choppy Waters Ahead: Trade Wars and Regional Risks in Global Logistics

Rag News: Store Returns, LATAM Opportunities & Ghana’s Stand

Building Long-Term Supplier Relationships in the Secondhand Wholesale Industry: A Buyer’s Guide

How Bulk Buying Secondhand Clothing Can Boost Margins and Sustainability

Women in the Circular Economy: Driving Innovation and Growth in the Secondhand Industry

Beyond Fast Fashion: How Extended Producer Responsibility (EPR) is Reshaping the Secondhand Market

Rag News: Key Trends, Secondhand Markets & Sustainability Efforts

Maximizing Profitability in Secondhand Wholesale: Strategies for Sourcing, Pricing, and Market Expansion

Beyond Carbon Neutral: Innovating for Positive Climate Impact in Secondhand Fashion

The Role of the African Market in the Global Secondhand Clothing Trade

Changing Consumer Perceptions: The Biggest Challenge in the Secondhand Wholesale Industry

Secondhand Textile Trade in Emerging Markets: The Next Frontier

The Future of Used Clothing Trade in Latin America: Market Entry & Compliance Strategies

The Global Market for Used Shoes in 2025 – Part 2

Africa’s Growing Demand for Secondhand Clothing: Opportunities & Challenges

Rag News: Circular Economy Insights: SMART Recap, Key Reports & Industry News

Rag News: Your Monthly Update on Secondhand Industry Trends

What Does Working With Bank & Vogue Look Like As A Buyer?

Rag News: Strategies for Port Disruptions + Industry Highlights

Rag News – Your Essential Market Update: Industry Insights and Innovations

Shared Responsibility in the Circular Economy: Who Owns the End of a Product’s Life?

2025 Consumer Behavior Shifts: How Circular Fashion is Redefining Brand Loyalty

Secondhand Retail’s Role in Achieving Net Zero: Carbon Offsetting and Emission Reduction Strategies

Trade Tensions Escalate: U.S. Tariffs Trigger Global Economic Ripples

How Second-Hand Wholesale is Changing the Retail Landscape

2025 Secondhand Collectors and Charities Toolkit

Navigating the Grey Market: Implications for Luxury Resale

Upcycling Innovation: How Circular Design is Impacting Fashion Waste Reduction

The Financial Impact of Upcycling and Value-Added Services on Secondhand Wholesalers in 2025

The Impact of Upcycling on Brand Perception and Sales

Holiday Gift-Giving & Why Second-Hand Is the Ultimate Sustainable Choice

The Eco-Friendly Retailer’s Guide to Wholesale Second-Hand Buying for 2025

Cross-Border Trade Regulations and Market Dynamics in the Global Secondhand Market (2025 Enhanced Edition)

Regulatory and Compliance Challenges in the Secondhand Industry

Convivios en Guatemala: Una Guía para Celebrar la Navidad de Forma Tradicional y Sostenible

Seasonal Trends in Secondhand Goods: What to Stock and When

Rag News: Port Updates, New Laws & Circular Economy Tips for Wholesalers

USEC Port Strike Update: What the Tentative Agreement Means for Your Supply Chain and How to Prepare

The Legal Side of Secondhand Goods: Essential Insights for Wholesalers

How To Furnish Your Home For The Holidays Using Second-Hand Finds

The Role of Technology in Transforming Secondhand Wholesale

Rag News: Inside Bank & Vogue’s Annual Meeting + The Future of Recycled Fashion

5 Old and New Ways to Make Business in Wholesale Secondhand Industry

The Ethical Fashion Movement Explained

From “Waste” to Wardrobe: The Journey of Recycled Textiles

Sustainable Business Practices in the Secondhand Goods Industry

Sustainability: How Returns and Excess Inventory Drive Change

Tips for Charities and Private Collectors in the Wholesale Secondhand Goods Industry

Rag News – Boost Your Profits in the Secondhand Market!

Maximizing Profits: Effective Strategies for Secondhand Goods Wholesalers

Store Return Pallets for Sale: Your Guide to Buying Wholesale

10 Overconsumption Facts That Will Make You Rethink Your Purchasing Decisions

Building Strong Wholesale Supplier Relationships

Trends in Secondhand Goods: Analyzing Current Trends in the Secondhand Market

Economic and Environmental Benefits of Secondhand Clothing Markets

Rag News – Vintage vs. Modern: What Sells Best in the Secondhand Market?

Vintage vs. Modern: What Sells Best in the Secondhand Market?

The Conscious Consumer: How to Make the Most Ethical Choices

Second-Hand Shopping Tips for Thrifting

Whispers in the Market: Could Argentina Soon Welcome Second-Hand Clothing Imports?

The Journey of Second-Hand Toys from Collection to Resale

The Global Graded Goods Market – How Do Regions Across The World Vary?

Exploring the Global Market & Sustainability of Second-Hand Shoes

Breaking News: Bank and Vogue Offers Full Containers of Second-Hand Pet Goods at Unbeatable Prices!

Green Threads: The Environmental Impact of Credential Clothing

The World of Graded Goods: Understanding Second-Hand Clothing Grading

Discover the buying and selling of Bric-Brac through Bank & Vogue

The World of Bric-à-Brac: A Treasure Trove of Sustainability

Used Toys & The Circular Economy – How Pre-Loved Toys Help Us Save Money & The Environment

Global Wholesale Used Clothing Statistics & Information For 2024

SMART: Reflecting on Steven’s Keynote speech

Converse Renew Upcycled Shirts

History of Polar Fleece

Bank & Vogue hosts biggest ever Latin America Secondhand Textiles Summit

Rag News: November 2021

Rag News: October 2021

Rag News: August 2021

Rag News: July 2021

Rag News: June 2021

Rag News: May 2021

Helping those in need, one sustainable mask at a time.

Beyond Retro and Bank & Vogue are thrilled to share our involvement in the latest Converse Renew launch – the limited-edition Converse Renew Tropical Shirts Chuck 70.

Rag News: April 2021

Rag News: March 2021

Rag News: February 2021

Rag News: December 2020

Rag News: November 2020

A Partnership towards a more Sustainable Future.

Rag News: October 2020

Rag News: September 2020

Rag News: August 2020

Rag News: July 2020

Rag News: June 2020

Best Practices to face COVID-19

Rag News: May 2020

The second life of Used Clothing during COVID-19 Pandemic

Rag News: Special Coronavirus Edition

The Bulletin

Rag News: April 2020

Keep donating, people are still in need.

Honoring Japan’s Kimono

Rag News: March 2020

A client visit to Guatemala

Creating a better world for our Kids

Rag News: February 2020

Creating a Sustainable Future: How Used Clothing Contributes to the Circular Economy

Not Just Used Clothing: We Deal in Used Shoes, Belts, Purses & More

How Used Clothing Brokers Buy & Sell Bulk Used Clothing

Bank & Vogue and Return-It Unite for Sustainability

How We Sell Used Shoes as Used Clothing Brokers

What You Can Do with Unused Holiday Decorations

How to Get the Most for Your Retail Returns

How We Facilitate Global Logistics as a Used Clothing Broker

The Global Market for Used Shoes in 2020

Rag News: November 2019

How Secondhand Toys Make Their Way Across the World

The International Market for Used Purses

What is Our Role as a Recycled Clothing Seller?

Rag News: October 2019

Mixed Rags: Finding a 2nd, 3rd or Even 4th Use for Clothing

Sorting Out the Clothing Terms: Vintage, Used, Secondhand, & Retro

Rag News: September 2019

The Global Credential Clothing Market for 2020

Sustainability News: The Innovative Post-Consumer Denim Sneaker

An Alternative to Buying New Clothing and Throwing It Away Quickly

Benefits for the Environment When You Shop for Clothing Online

The Jeans Redesign: A Sustainable Fashion Future

The Importance of Recycling Textiles

Rag News: July 2019

Why the UK Is One of the Best Textile Reusing & Recycling Countries in the World

Family Plan for the Summer: Upcycling Your Clothes!

What Happens to Your Unwanted Clothing, Shoes & Toys?

Rag News: June 2019

Environmental Benefits of Donating Clothing: Do Something Good for You, for Others, and for the Environment

Spring Cleaning: How to Donate Used Clothing & Other Goods

Circular Economy: What We Stand to Lose & How the Fashion Industry Can Help

Used Goods & Mixed Rags: If You’re Not Using It, Put It Back into Circulation

How Mixed Rags Are Prepared for Safe Further Distribution

What Happens When Wholesale Used Clothing Is Shipped Overseas

Companies Making Waves in the Circular Economy

How Used Clothing Is Sorted & Graded – The Journey of Credential Clothing & Mixed Rags

Rag News: April 2019

The Continued Journey of Used Credential Clothing – How & Where We Ship

Mixed Rags and Their Importance in the Global Circular Economy

When It Doesn’t Spark Joy, Even for Charities or Thrift Stores

Helene Carter, New Elected Member of the Board of Directors of SMART

Rag News: March 2019

Increasing Used Clothing Collection through Participating Return-It Depots

Bank & Vogue’s Role in the Circular Economy: A Sustainable Model for Future Fashion

Beyond Retro: Finding a New Purpose for Clothing in the Circular Economy

Marie Kondo, Mixed Rags & Solving the Crisis of Stuff with Joy

Rag News: February 2019

The Worldwide Journey of Credential Clothing

Groundbreaking Project to Prove that Fashion Can Be Circular

Definitions and Visions for the New Year

Rag News: January 2019

New Year’s Resolutions for Fighting the Crisis of Stuff

The Benefit of Credential Clothing For Vintage Retailers

How Credential Clothing Is Unique In The Wholesale Industry

Rag News: December 2018

The Solution to the Fast Fashion Crisis

Familiarizing Yourself with the Credential Clothing Market and Its Value

Making Alternative Use of Mixed Rag Options

Turning Your Halloween Items Into Credential Gold

The Urgency Of Improving Textile Recycling

Rag News: November 2018

Credential Clothing For Those in Crisis

Clothing & Reaching The UN’s Climate Goals

Rag News: October 2018

The Modern State of the Mixed Rag Market

Rag News: September 2018

How Consumers Can Help the “Crisis of Stuff”

Recycling Mixed Rags is a Mixed Bag

Credential Clothing & The Sustainable Fashion Movement: What The Future Holds

Rag News: August 2018

Disposable Fast Fashion and the Crisis of Stuff Needs a Mixed Rags Answer

Rag News: July 2018

Knowing What Makes an Item “Credential”

Mixed Rags May Become Jet Fuel by the Year 2020

Addressing Disposable Fast Fashion with a Mixed Rags Solution

The Cost Benefits of Credential Clothing

Addressing Textile Ethics One Mixed Rag at a Time

Mixed Rags as the Answer to Fast Fashion

Rag News: June 2018

Credential Clothing as a Part of the Solution to the Consumption Crisis

The Growth Curve Possibilities of a Mixed Rags Market

The Road Taken: How Credential Clothing Makes an Epic Journey

Rag News: May 2018

Mixed Rags: A Global Benefit for a Sustainable Environment

For the Love of Credential Clothing: A Solution to the “Crisis of Stuff”

How Mixed Rag Clothing Can Address the ‘Crisis of Stuff’

Rag News: April 2018

How Recycling Credential Clothing is Beneficial to Consumers

The 4-1-1 About Mixed Rags and Mixed Rag Markets

Rag News: March 2018

Vintage Purchases and the Value of a Vintage “Story”

What Benefits Can Buyers Find in Mixed Rags?

The Financial and Environmental Benefits of Giving Life to Old Materials

Rag News: February 2018

Getting Familiar with Credential Used Clothing

Attention Buyers and Shoppers: How To Know the Difference Between Thrifty and Vintage Shopping

The Benefits of Shopping the Thrifty Way (for Shoppers and for Thrift Shops)

Rag News: January 2018

Reducing Waste through Repurposing Vintage Items

What You Need To Know About Credential Clothing

Rag News: December 2017

What You Need to Know About Purchasing A New Pair of Vintage Shoes

Rag News: November 2017

Buying and Supplying in the Vintage Clothing Market

Being a Responsible Consumer: The Art of Textile Recycling

Buy Vintage: Responding to the Problem of Textile Waste

Used, Vintage, Retro, Second-Hand: What’s the Difference?

Book Recycling: Giving Old Books New Life

Can We Solve the Crisis of Stuff?

Textile Recycling 101: All You Need To Know About How to Divert More Material from Landfills

Helping Give New Life to the World’s Used Purses, Shoes and Belts

Seamless, No-Hassle, On-Time: The Bank & Vogue Way

Holiday Season Approaching; Overstock and Returned Toys Need to Go! But Where?

Help Alleviate The Crisis of Stuff: How to Avoid Sending Used Goods to Landfill (And Make Money!)

The Crisis of Stuff by Steven Bethell

Tips for Managing Relationships With Buyers

Baler Buying Guide – Maximizing The Value Of Your Investment

Dealing With Donated Shoes – Capturing Cashflow

Optimize Cashflow From Mixed Rags and Credential Clothing

Sourcing Wholesale Store Returned Merchandise With Bank & Vogue

Selling Your Mixed Rags With Bank & Vogue – Cashflow for Charity and Second Hand Clothing Retailers

Loading A Shipping Container – 3 Principles To Remember

4 Tips to Improve the Efficiency of Reverse Logistics Processing

Working With Us – More Than Just Clothing Recycling

Connecting Communities, Promoting Prosperity

A SMART Association For Your Business and The Environment

Sourcing and Selling Credential Clothing and Mixed Rags with Bank & Vogue

Fixing a Fashion Crisis – Beyond Retro and Bank & Vogue

Bank and Vogue : Driving Sustainability AND Profit For Clothing Retailers

Store Returns and Recycling: Mitigating Loss, Protecting the Environment

The Front Lines of A Fast Fashion Revolution – Bank and Vogue

Start the New Year Off Green!

If Recycling Nylon is So Good for the Planet…Why Don’t More Companies Do It?

Take an Eco-Vacation this Winter

Nike Creates from Recycled Materials

New Fabric Inspired by Nature Repairs Itself

Changing Our Disposable Clothing Culture

New Tech Targets Shipping Efficiency

Simplifying Sustainable Fashion

Debunking Eco Fashion Myths

Stay Warm this Winter with Thrift

Sustainable Fashion – Good for the Planet and Your Wallet

Bank & Vogue is a ‘True Blue’ Business

New to the idea of recycled fashion? Here’s What You Need to Know

What to Avoid Buying at the Thrift Store

The Textile Recycling Industry is Setting New Standards

Ten Brands Doing Sustainable Cotton Right

Fast Fashion’s Rapid Growth is Slowing Down

Understanding the Circular Economy – the Design Stage

Questions You Should be Asking About Sustainable Fashion

The Karuna Orphanage needs a study hall

Shop Thrift for Back to School

The Importance of Fair Fashion

Designing Fashion for a Longer Life

The Power of Crowd-Sourced Clothing Design

Microorganisms for Sustainable Fashion
Eco Fashion Can Benefit from Eco Logistics

Store Returns – One of the Biggest Challenges for Retailers

Loading 40 Foot High Cubes

Guidelines for Loading 53′ Trucks

Beyond Retro Fashion gets the Vogue Magazine Royal Treatment

Important New Shipping Requirements

SMART on the Decreased Demand for Used Clothing

Karuna Orphanage Winter 2015

What Can Brokers Do For You?

Scott’s 5 Year Anniversary!

Scott, Four Sellers and a Customer in Montreal

Jorge & Lawrence’s Expedition to the Border

Jose & Alice visit Georgia and SVDP Hope in Action

How Can Christmas Sweaters Help Save Children?

Market Outlook – August 2014

Warehouse Health & Safety

Goodwill Conference in Orlando Florida

Ongoing Customer Service Training

5 Misconceptions about Shipping & Logistics

10 Things We Can Teach You About Packaging

Bank & Vogue attends Annual SMART Convention

Collection Bins: Charities vs. Private Collectors

Scott & Lawrence Hit Miami FL!

Encouraging Voluntary Compliance –Health and Safety Guidelines

Bank & Vogue Proudly Sponsors The SMART Recycling Rangers

Clothing and Textile Recycling Has Major Impact on Reducing Greenhouse Gasses According to EPA and S.M.A.R.T.

Seller Consultant Alice Travels to North East

Thrift-Shop Steals

Donations: Usable or Junk?

Why We Should Re-use


Menu
Subscribe to the Rag News











